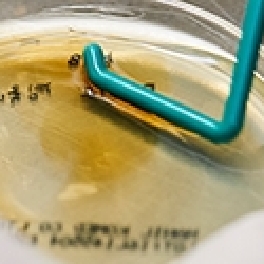

건강한 성장 관리는 정확한 진단이 우선입니다.
-

아이의 성장 상태 진단 -

1:1 맞춤 치료
성장에 도움되는 한약재가 1포에
성장클리닉 시럽은 소화기, 숙면, 체력, 성장에 도움이 되는 한약재로 구성됩니다.
-

구기자
-

맥아초
-

산사
-

산약
-

속단
-

오가피
-

용안육
-

우슬
-

황기
위 처방에 사용되는 한약재는 의약품용 한약재로, 대한민국약전 및 생약규격집의 기준에 따라 식약처의 엄격한 관리를 통해
한약재 제조 및 품질관리기준(GMP) 승인받은 한약재만 사용합니다.
-

한약재 검사 항목
중금속검사, 잔류농약검사, 이산화황검사, 곰팡이독소검사, HPLC검사, 관능검사
논문으로 입증 된
한약의 성장 효과
-

“성장 효과가 높은 한약 보양성장탕”
보양성장탕을 복용한 환아의 신장백분위가 증가하였고, 15개월 이상 치료 받으면 신장 성장효과를 기대할 수 있다.
대한한방소아과학회지, 26(2):62-71, 2012
-

“식욕부진 등 소화기계 증상 한방치료 시 성장효과 입증”
소화불량, 식욕부진 등의 소화기 증상 개선을 위한 한약을 복용한 결과 성장에 유의한 효과를 보였다.
대한한방소아과학회지, 27(4):50-56, 2013
성장클리닉 시럽도
함소아가 만들면 다릅니다.

성장클리닉 시럽은 짜먹는 타입의 연조엑스제 처방으로 아이들이 복용하기 쉽습니다.
성장클리닉 시럽 처방이 필요한 순간
-
Check 01
밥을 안 먹는 증상이
지속되고 있어요. -
Check 02
또래보다 성장이
느려요. -
Check 03
잔병치례로 소진된 에너지 공급이 필요해요.
-
Check 04
사춘기 급성장
시기예요. -
Check 05
무리한 학업스케쥴로
성장이 뒤쳐져요. -
Check 06
예민하고 숙면을
취하지 못해요. -
Check 07
키도 작고, 체력이
약해요.
초등학교 입학 전, 2학기 시작 가을 무렵,
사춘기 시작 단계에
인기 폭발하는
스테디 item!
왜 2학기 시작 가을 무렵에 인기가 많을까?
"올해는 크겠지.."라고 미뤘기 때문입니다.
성장은 시기가 있기에 지금이 제일 빠른 타이밍!
-

7살 우리 딸 키가 멈춤 단계인지 작년부터 키가
그대로네요. 키 쑥쑥 크고 건강하게 해주세요! -

키도 키지만 전반적으로 건강해지고
탄탄해지고 싶어요. -

성조숙증으로 호르몬 치료 받고 있는 우리 아이.
성장클리닉 키커 시럽으로 성장에 대한 고민 말끔히 사라지게 해주세요! -

12세, 초경을 시작한 우리 딸. 앞으로 더 커야 할 텐데..
더 늦기 전에 성장클리닉 키커 시럽 시작해도 될까요? -

밤만 되면 잠이 안 온다며 늦게까지 노는 우리 아이..
숙면을 취해야 많이 클 텐데 걱정이네요.
자주 하시는 질문!
한의사가 직접 답해드려요.
-
A키에 있어서는 유전적인 요인이 중요하지만, 후천적인 요소도 약 10cm 이상의 키 성장을 좌우합니다.
함소아 성장클리닉 시럽은 성장에 도움을 주는 약재인 구척과 오가피, 우슬, 속단이 함유되어 있어 성장에 도움을 줍니다.
실제 실험 연구 결과에서 구척추출물 투여시 대조군에 비해 56.3% 더 성장하는 결과를 보였습니다.
성장클리닉 시럽과 꾸준한 운동을 병행하면 성장에 큰 도움이 됩니다.
-
A네. 함께 복용해도 좋습니다. 칼슘뿐 아니라 비타민D 등 다른 평소 복용하던 영양제도 꾸준히 같이 복용해 주세요. 문의 사항이 있으시면 주치의 한의사 선생님과 상담을 진행해주세요.
-
A성조숙증은 급성장시기가 당겨져서 당장은 더 빨리 잘 크는 것처럼 보이지만 일찍 성장이 멈춰서 최종 키는 더 작아질 수 있습니다.
또한 소아비만의 경우 성조숙증의 위험을 높이게 되어 최종 키에 영향을 끼칠 수 있습니다.
다만, 식사량을 엄격하게 제한할 경우 키 성장이 방해되고 신경성 식욕부진이 생길 수 있습니다.
따라서, 비만도가 심각하지 않다면 적절한 관리와 운동 등을 통해 3개월간 몸무게는 유지하면서 키는 잘 크도록 돕는 것이 좋습니다. -
A최소 3개월 이상 장기적으로 꾸준히 복용하는 것을 추천드립니다.
성장클리닉 키커 시럽에는 키 성장에 도움되는 오가피, 구척, 속단, 우슬 등의 약재뿐 아니라 소화 흡수를 도와주는 산약, 산사 등의 약재와 숙면을 도와주는 용안육, 체력을 보강해주는 황기, 구기자 등의 약재가 들어있어 키성장 뿐만 아니라 전반적인 건강증진에도 도움이 됩니다.
처방 받으셨다면?
이유 있는 자신감, 함소아 App에서 약재&처방전 공개 시스템을 확인하세요!
-

함소아 어플은
구글 플레이스토어 및 아이폰 앱스토어에서 무료로 설치할 수 있습니다.

